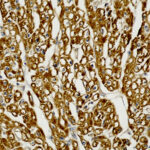
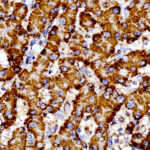
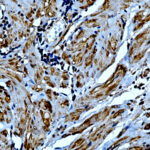

|
|---|
 Anti-SDHB [SDHB/6697R] Anti-SDHB [SDHB/6697R]Buy here |
 Anti-SDHB, Clone SDHB/2382 Anti-SDHB, Clone SDHB/2382Buy here |
 Anti-Secretin Anti-SecretinBuy here |
 Anti-Serum Amyloid A Anti-Serum Amyloid ABuy here |
 Anti-Serum Amyloid P, Clone APCS/3240 Anti-Serum Amyloid P, Clone APCS/3240Buy here |
 Anti-SFTPD Anti-SFTPDBuy here |
 Anti-SLAMF7 Anti-SLAMF7Buy here |
 Anti-SLAMF7 Anti-SLAMF7Buy here |
 Anti-SMAD4 Anti-SMAD4Buy here |
 Anti-Smoothelin, Clone C-8 Anti-Smoothelin, Clone C-8Buy here |